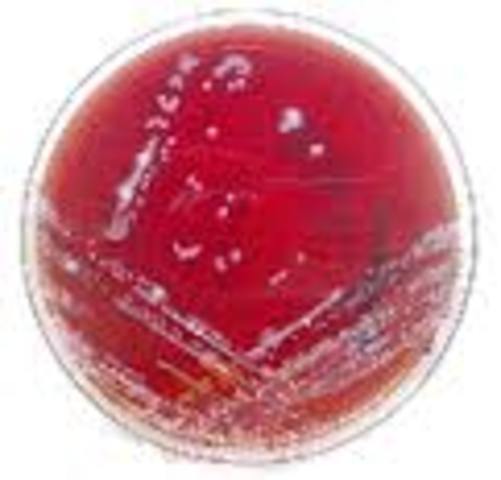
Introducción de los indicadores de PH en los medios de cultivo

-
Zacharias Janssen,
-
Robert Hooke,Hooke descubrió las células observando en el microscopio una lámina de ... Lo que estaba observando eran células vegetales muertas con su característica forma poligonal.
-
Marcello Malpighi,Tenía una gran capacidad de observación, estudioso de plantas, insectos, tejidos animales, embriones y órganos humanos al microscopio. por esos sus obserbaciones del material biologico
-
fue el primero en refutar la teoria dela jeneracion espontanea en gusanos
-
Primera vacuna contra la viruela de Edward Jenner
-
asocia por primera vez la presencia de un hongo a una enfermedad (malasegno) presente en gusanos de seda.
-
-
Miles Joseph Berkeley descubre un hongo (Phytophthora infestans) que produce la podredumbre de la patata.
-
Eichstedt, identifica por primera vez a un microorganismo, un hongo.como el agente etiológico de una enfermedad cutánea humana (pitiriasis versicolor).
-
realiza el primer estudio epidiomoligico del colera en londres
-
demuestra que el carbunco o antras son causados por el basilus anthrasis
-
Lister logra el aislamiento de bacterias lacticas en un medio liquido mediante dilucion
-
observa que la fiebre amarilla es transferida por mosquitos
-
Este método fue un aliciente para que Gram comenzara sus experimentos con la tinción de bacterias. Paul Ehrlich
-
descubre la vacuna de la rabia. Inocula saliva de un perro rabioso a un conejo, deseca la médula y la inocula al hombre (al principio fuertes problemas secundarios).
-
descubre el echerichia coli
-
introduce el uso de las cajas de petri en la microbiologia
-
Bruce inicio investigaciones de Melitococo
-
Beijerinck aísla bacterias fijadoras de nitrógeno de los nódulos presentes en las raíces de leguminosas.
-
estudia las bacterias de azufre y las bacterias nitrificantes
-
Wurtz
-
Dmitri Iosifovich Ivanovski
fue un biólogo ruso, el primer científico en descubrir los virus -
confirma que la fiebre amarilla es transmitida por mosquitos
-
descubre el virus retrovirus que produse tumores, sarcomas en pollos
-
aisla la pinicilina de un cultivo de un cultivo de piniciliuns
-
descubre el fenómeno de la antibiosis.
-
desarolla el microscopio de contraste de que permiten observar microorganismos
-
inventa el microscopio electronico
-
descubre las sulfaminas el primer agente quimioterapeutico
-
aleja de estrectimicina de un cultivo streptomicis
-
induse el concepto de plasmida
-
aisla los TRNA moleculas que incorporan los aminoacidos activaods en las proteinas
-
pone a punto un test bacteriano para detectar mutagenos y carcinogenos:el test de ames
-
pone a punto un test para detectar mutajenos y carcinojenos
-
Woese y George E. Fox reconocen las archeas como el tercer dominio de los seres vivos.
-
W. Gilbert & F. Sanger, desarrollaron un método para secuenciar ADN basado en la modificación química del ADN y posterior escisión en bases específicas
-
descubre los priones agentes causantes de encelopatia
-
Robert Gallo y Luc Montagnier llevan a cabo el aislamiento e identificación del virus del sida.
-
utilizo la polimeraza para llevar a cabo la PCR( reaccion de cadena de la polimeraza)
-
Gérmenes vivos.,dice que las enfermedades contagiosas se deben a "gérmenes vivos" que pasan de diversas maneras de un individuo a otro; pero la "cosa" que se transmite en la enfermedad siguió siendo objeto de conjeturas durante mucho tiempo.
-
observa por primera vez la presencia en la sangre de animales enfermos de un microorganismo patógeno, Bacillus anthracis.
Looking for a timeline maker?
Create timelines for projects, roadmaps, history, lessons, legal cases, and stories with Timetoast. Timetoast is a timeline maker for work, school, research, and stories.